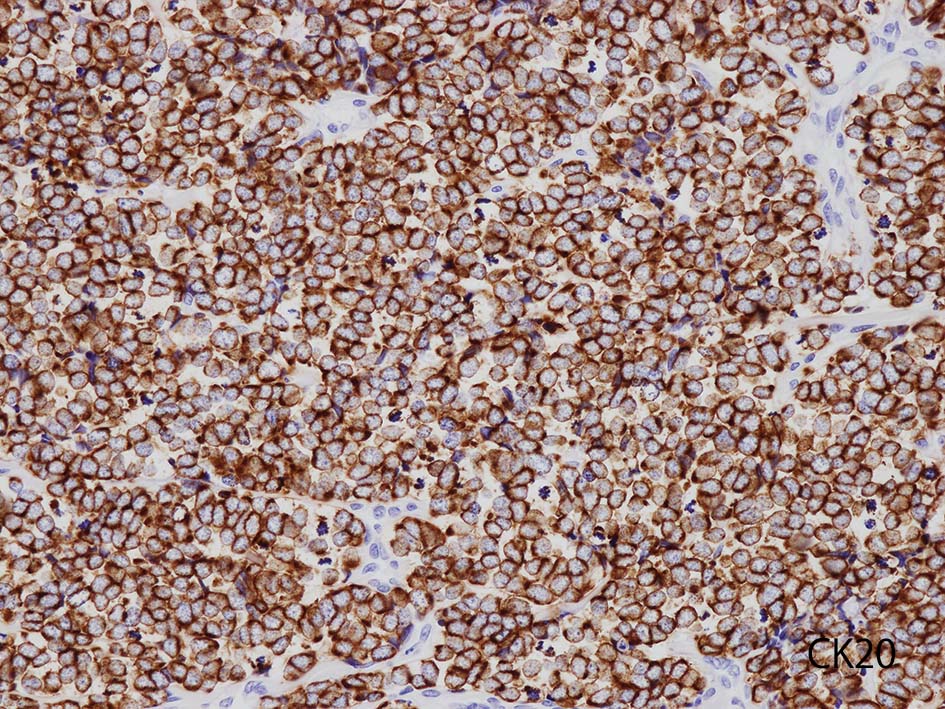

Wikipathologica-KDP
Merkel cell carcinoma メルケル細胞癌†
作成中ページ
Merkel cell carcinoma†
高齢者の露光部に好発する皮膚原発の神経内分泌腫瘍.
1972年 Tokerがtravecular carcinoma of the skinとして初めて報告し,
1978年にTangとTokerが電顕的に皮膚 Merkel細胞に特徴的な分泌顆粒が観察され腫瘍発生母地としてMerkel cellが考えられるようになった.(歴史的経緯)
Merkel cell由来は電顕所見やimmunophenotypeの類似性等から推察されてきたが, Merkel cell由来を疑問視する意見もある.
腫瘍由来細胞の候補は, Merkel cellの他, Merkel cellの前駆細胞(表皮幹細胞, 毛包幹細胞), 神経系由来細胞, pre-B/ pro-B細胞, 線維芽細胞などが考えられているが組織発生の詳細はいまだ不明な点が多く, 結論には至っていない.
病因
近年の研究で, メルケル細胞ポリオーマウイルス(MCPyV)感染, 長期紫外線暴露, HIVや免疫抑制剤による免疫抑制状態の持続, Rb1やTP53遺伝子などがん抑制遺伝子体細胞変異などが病因として考えられている.
メルケル細胞ポリオーマウイルス(MCPyV)†
- 2008年 Fengらは, Merkel細胞癌のゲノムを調べ, 新種のポリオーマウイルスであるMCPyVを同定した.
- MCPyVはエンベロープ(envelope)をもたない, 正二十面体の小型2本鎖DNAウイルスで5387塩基対のゲノムからなる.
- 初期遺伝子には腫瘍タンパクのlarge T(LT)抗原とsmall T(ST)抗原が, 後期遺伝子には外殻構造(カプシド)タンパクであるVP1, VP2, VP3がコードされウイルスを構成している.
- ウイルスゲノムは腫瘍細胞のゲノムに単クローン性に組み込まれている.
- MCCのLT抗原コード領域では, Rb結合領域とヘリカーゼドメインとの間に終止コドンを生じる特異的短縮型変異が認められ, それにより生じたMCPyV由来 LT抗原はヘリカーゼ活性が消失しておりウイルス複製能はなく宿主細胞溶解はおこらない.
- Rbとの結合領域は保たれており, Rbタンパク結合ドメイン(LxCxE motifとも呼ばれる)領域に, がん抑制遺伝子RB1がコードするRBタンパクを結合させる. 結果RBタンパクが不活化し細胞周期亢進による腫瘍細胞クローン性増殖を誘導, Merkel cell carcinoma発生のイニシエーションとなると考えられている.
sT抗原に関しても同様に発がん促進作用を示唆する結果が報告されている.
- MCPyVは多数のヒトが無症候性に感染しているありふれたウイルスであり, 一般人口の半数以上はMCPyVカプシド抗体を有している. また, MCPyVのDNAは健常人皮膚で高頻度に検出されている. 感染者のうちMCCを発症するのはごく一部.
- MCPyVカプシド抗体陽性は既感染を示し健常人の多くが陽性. 一方, MCPyV腫瘍タンパクに対する抗体保有は健常人ではまれであり, MCC患者では50%以上に検出されバイオマーカとしての有用性が示唆される.11
- Paulsonらの報告では, 診断時抗腫瘍タンパク抗体陽性患者では, 再発リスクが低い. 抗体価は治療後に急速に低下するが再発時には上昇した. 臨床的再発に先んじて抗体価上昇がみられる症例もあった.
- 腫瘍タンパクは自然免疫反応回避にも関与し, toll-like receptor 9の発現を抑制することが報告されている.
MCPyV陰性Merkel cell carcinoma†
- MCPyVはMerkel cell carcinomaの7-8割に検出され, MCC発がんにおいて重要な因子であるが, 一方で2-3割にMCPyVが腫瘍内で検出されないMCC症例も存在する.
- 核の多型性の強い症例はMCPyV陰性であることが多い.
- MCPyV陰性MCCの発がんメカニズムはいまだ不明な点が多い. TP53やRB1などがん抑制遺伝子の体細胞変異が病因と関連しているとする報告がありとくに紫外線に関連する変異が多い.7)桑本ら.
- MCPyV陽性例と陰性例の臨床像については, 陰性例は予後不良とする報告と予後に差はないという報告があり結論は一定ではない. 282例を多変量解析した最近の研究ではOSに有意差はないが陰性例では, 病勢進行リスクが高く, 腫瘍死が多かったとされている. 13) Moshili AS, et al.
病理組織学所見†
皮膚原発性Merkel細胞癌は 通常真皮を病変首座に増殖し, しばしば脂肪織まで浸潤する.
表皮とは連続性がなくGrenz zoneがみられるのが特徴であるが, 病理所見は多様であり, ときに表皮向性を示す症例やpagetoid patternを呈する症例もある.
非常にまれに, 表皮内や毛包内のみに病変を有する症例があり, T分類のTisに相当する.
典型的な腫瘍細胞は円形, 卵円形の比較的均一な形態で「salt-and-pepper」と称される微細顆粒状クロマチンを有する小型円形核をもつ. MCPyV陽性例が均一な小型円形核を呈する傾向があり, 陰性例では, 核多形性が目立つととする報告がある.
trabecular type, intermediate type, samll cell typeの3パターンの組織型に分類されているがしばしば混在している.
- trabecular typeは円形から多稜形の腫瘍細胞が索状に配列, 3形のなかで腫瘍細胞がもっとも大きく, 円形核と比較的豊富な細胞質をもつ.
- small cell typeは濃いクロマチン, 多形性を示す核をもつN/C比大の小型腫瘍細胞がびまん性に増殖する.
- intermediate typeではtrabecular, samll cell typeの中間の腫瘍細胞サイズを示す. 組織型としてはもっとも多い.
腫瘍内浸潤リンパ球/炎症細胞は多くの症例で認められる. リンパ球の腫瘍内浸潤は予後良好因子と報告されている. 16
MCCがときに有棘細胞癌など他の上皮系腫瘍と併存するが, これらの合併腫瘍は基本的にMCPyVが陰性である.
鑑別診断
肺小細胞癌を初めとする他臓器原発のneuroendocrine carcinomaの皮膚転移, 基底細胞癌, 毛芽腫, 悪性リンパ腫, 悪性黒色腫などがあげられる. 他臓器病変の検索に加えて以下免疫染色が有用である.
- 陽性上皮系マーカ; CAM5.2, AE1/3, CK20, BerEP4, EMA
- 陽性神経内分泌マーカ; chromograninA, synaptophysin, CD56, NES
- CK20の染色態度は核周囲にdot状にそまることが特徴的. (MCC[87%]のみではなく肺小細胞癌の4.6%にもこの陽性パターンをみることに注意*2)
TTF-1;肺小細胞癌の83-100%で陽性. Merkel cell carcinomaでは通常陰性であり, CK20のパターンとあわせて鑑別に有用である.
MCPyVの検索には抗LT抗体である, clone CM2B4の免疫染色が簡便かつ有用. ウイルス検出感度 0.88, 特異度0.94とされる. 13
症例 Merkel cell carcinoma of the skin, lower leg†
IWT case 80歳代 男性
skin biopsy virtual slide ---> Virtual Slideを見る. Sorry you need ID & psswrd to see the virtual slide.
下肢皮膚の赤色隆起性病変. 頂部の潰瘍部分より生検をおこなう.
 皮膚腫瘤
皮膚腫瘤
 loupe像 HE
loupe像 HE
 HE
HE
 HE
HE
 CK20
CK20
血管を間質にしてround cellsが索状に増殖する所見. rossett様配列がある. CK20は特徴的な dot-like patternを示す. クリックで大きな画像が見られます.
本例では, dot状だけでなく, 細胞周囲にも陽性像が認められる.
 HEx40
HEx40
 HE
HE
 HEx200
HEx200
 HEx200
HEx200
 HEx400
HEx400
免疫染色


 LCA
LCA
 chromograninA
chromograninA
 synaptophysin
synaptophysin
 CD56
CD56
MCpyV
MCpyV
CK(AE1/3); CK20は含まない, のほうがdot-likeな染まりをしている. CK20は膜にも陽性になっている. LCAは陰性. 神経内分泌マーカのchromograninA, synaptophysinは陽性.
本例ではCD56は淡くそまるのみであった. 浜松医大病院病理で染色していただいた, MCpvVは核に陽性となっている.
![[PukiWiki] [PukiWiki]](image/title-logo.png)
![[PukiWiki] [PukiWiki]](image/title-logo.png)